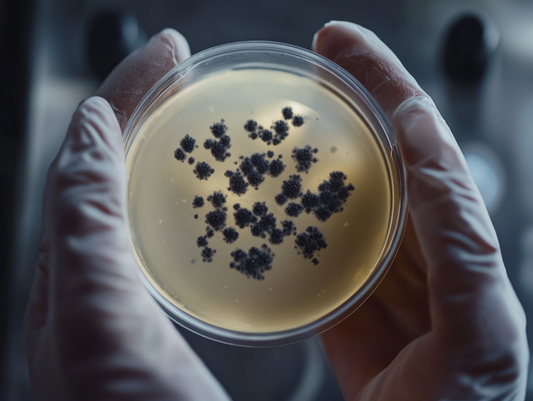

News

How to Prevent Streaking on Glassware in Your D...
If you've ever opened your dishwasher expecting spotless, crystal-clear glassware, only to find streaks and cloudy residue, you're not alone. Streaking on glassware is a common issue that can make...
How to Prevent Streaking on Glassware in Your D...
If you've ever opened your dishwasher expecting spotless, crystal-clear glassware, only to find streaks and cloudy residue, you're not alone. Streaking on glassware is a common issue that can make...
Citric Acid and Aspergillus Niger ("Black Mold"...
Citric acid is one of the most widely used food additives and cleaning agents in the world. Found in everything from soft drinks to dishwasher detergent, this naturally occurring compound...
Citric Acid and Aspergillus Niger ("Black Mold"...
Citric acid is one of the most widely used food additives and cleaning agents in the world. Found in everything from soft drinks to dishwasher detergent, this naturally occurring compound...

The Truth About Dishwashing Pods & Microplastic...
When you load your dishwasher, you expect your dishes to come out sparkling clean. But have you ever considered what’s being left behind? Many conventional dishwashing pods contain hidden plastics...
The Truth About Dishwashing Pods & Microplastic...
When you load your dishwasher, you expect your dishes to come out sparkling clean. But have you ever considered what’s being left behind? Many conventional dishwashing pods contain hidden plastics...

Sodium Bicarbonate: A Safe & Effective Ingredie...
When it comes to choosing a healthy, plastic-free, rinse aid-free dishwashing solution, it’s important to understand the ingredients that go into your cleaning products. At Minimalist Shine, we believe in...
Sodium Bicarbonate: A Safe & Effective Ingredie...
When it comes to choosing a healthy, plastic-free, rinse aid-free dishwashing solution, it’s important to understand the ingredients that go into your cleaning products. At Minimalist Shine, we believe in...

The Hidden Dangers of Commercial Rinse Aids
In our pursuit of sparkling clean dishes, many of us unknowingly expose ourselves to harmful chemicals lurking in commercial dishwasher rinse aids. While these products promise streak-free shine and faster...
The Hidden Dangers of Commercial Rinse Aids
In our pursuit of sparkling clean dishes, many of us unknowingly expose ourselves to harmful chemicals lurking in commercial dishwasher rinse aids. While these products promise streak-free shine and faster...